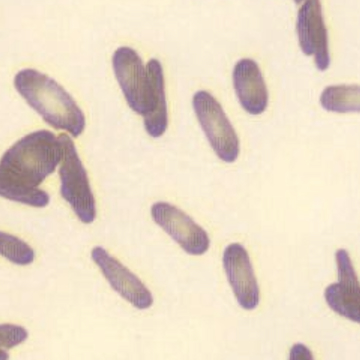

Howel-Jolly-like
Howell-Jolly-like inclusions in neutrophils are round, basophilic nuclear fragments that can be found in the cytoplasm of (mostly) neutrophils, but also very sporadically in that of monocytes. These nuclear fragments are in a sense analogous to the Howell-Jolly bodies found in erythrocytes. Howell-Jolly-like inclusions are a sign of dysplasia and have been described primarily in patients treated with immunosuppressants and antiviral drugs, as well as MDS. They are usually sparsely present (<5% of neutrophils).